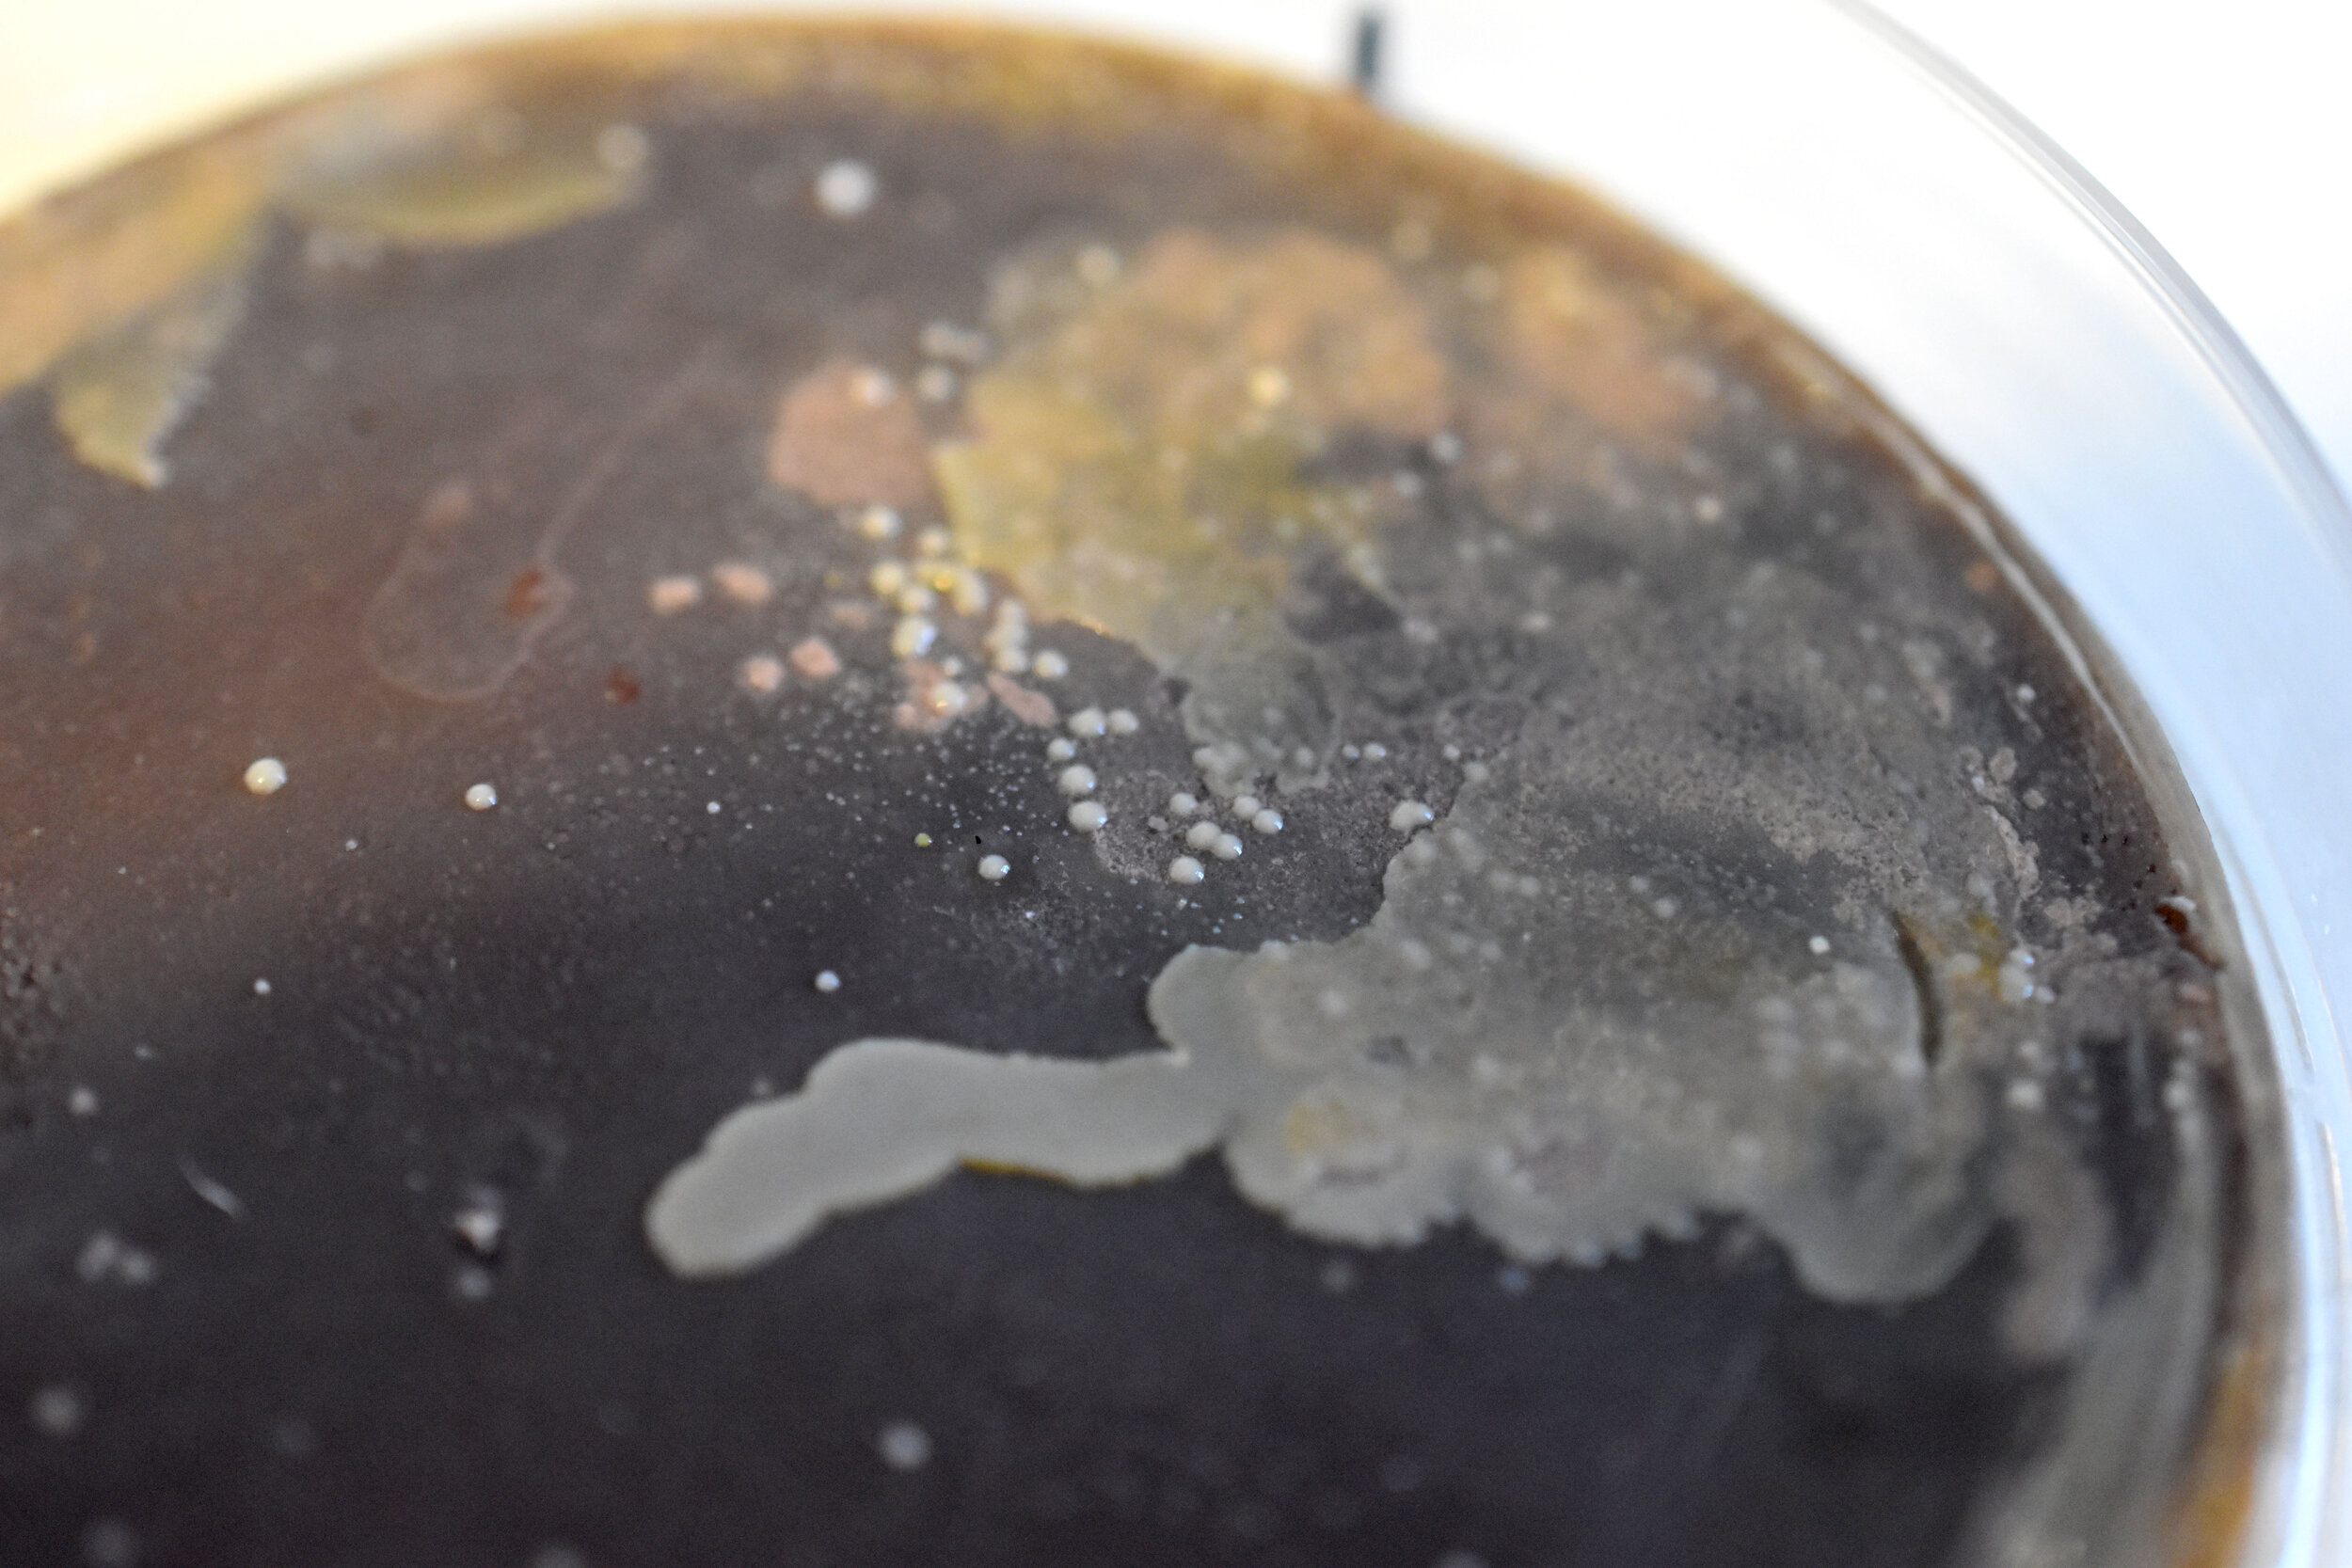
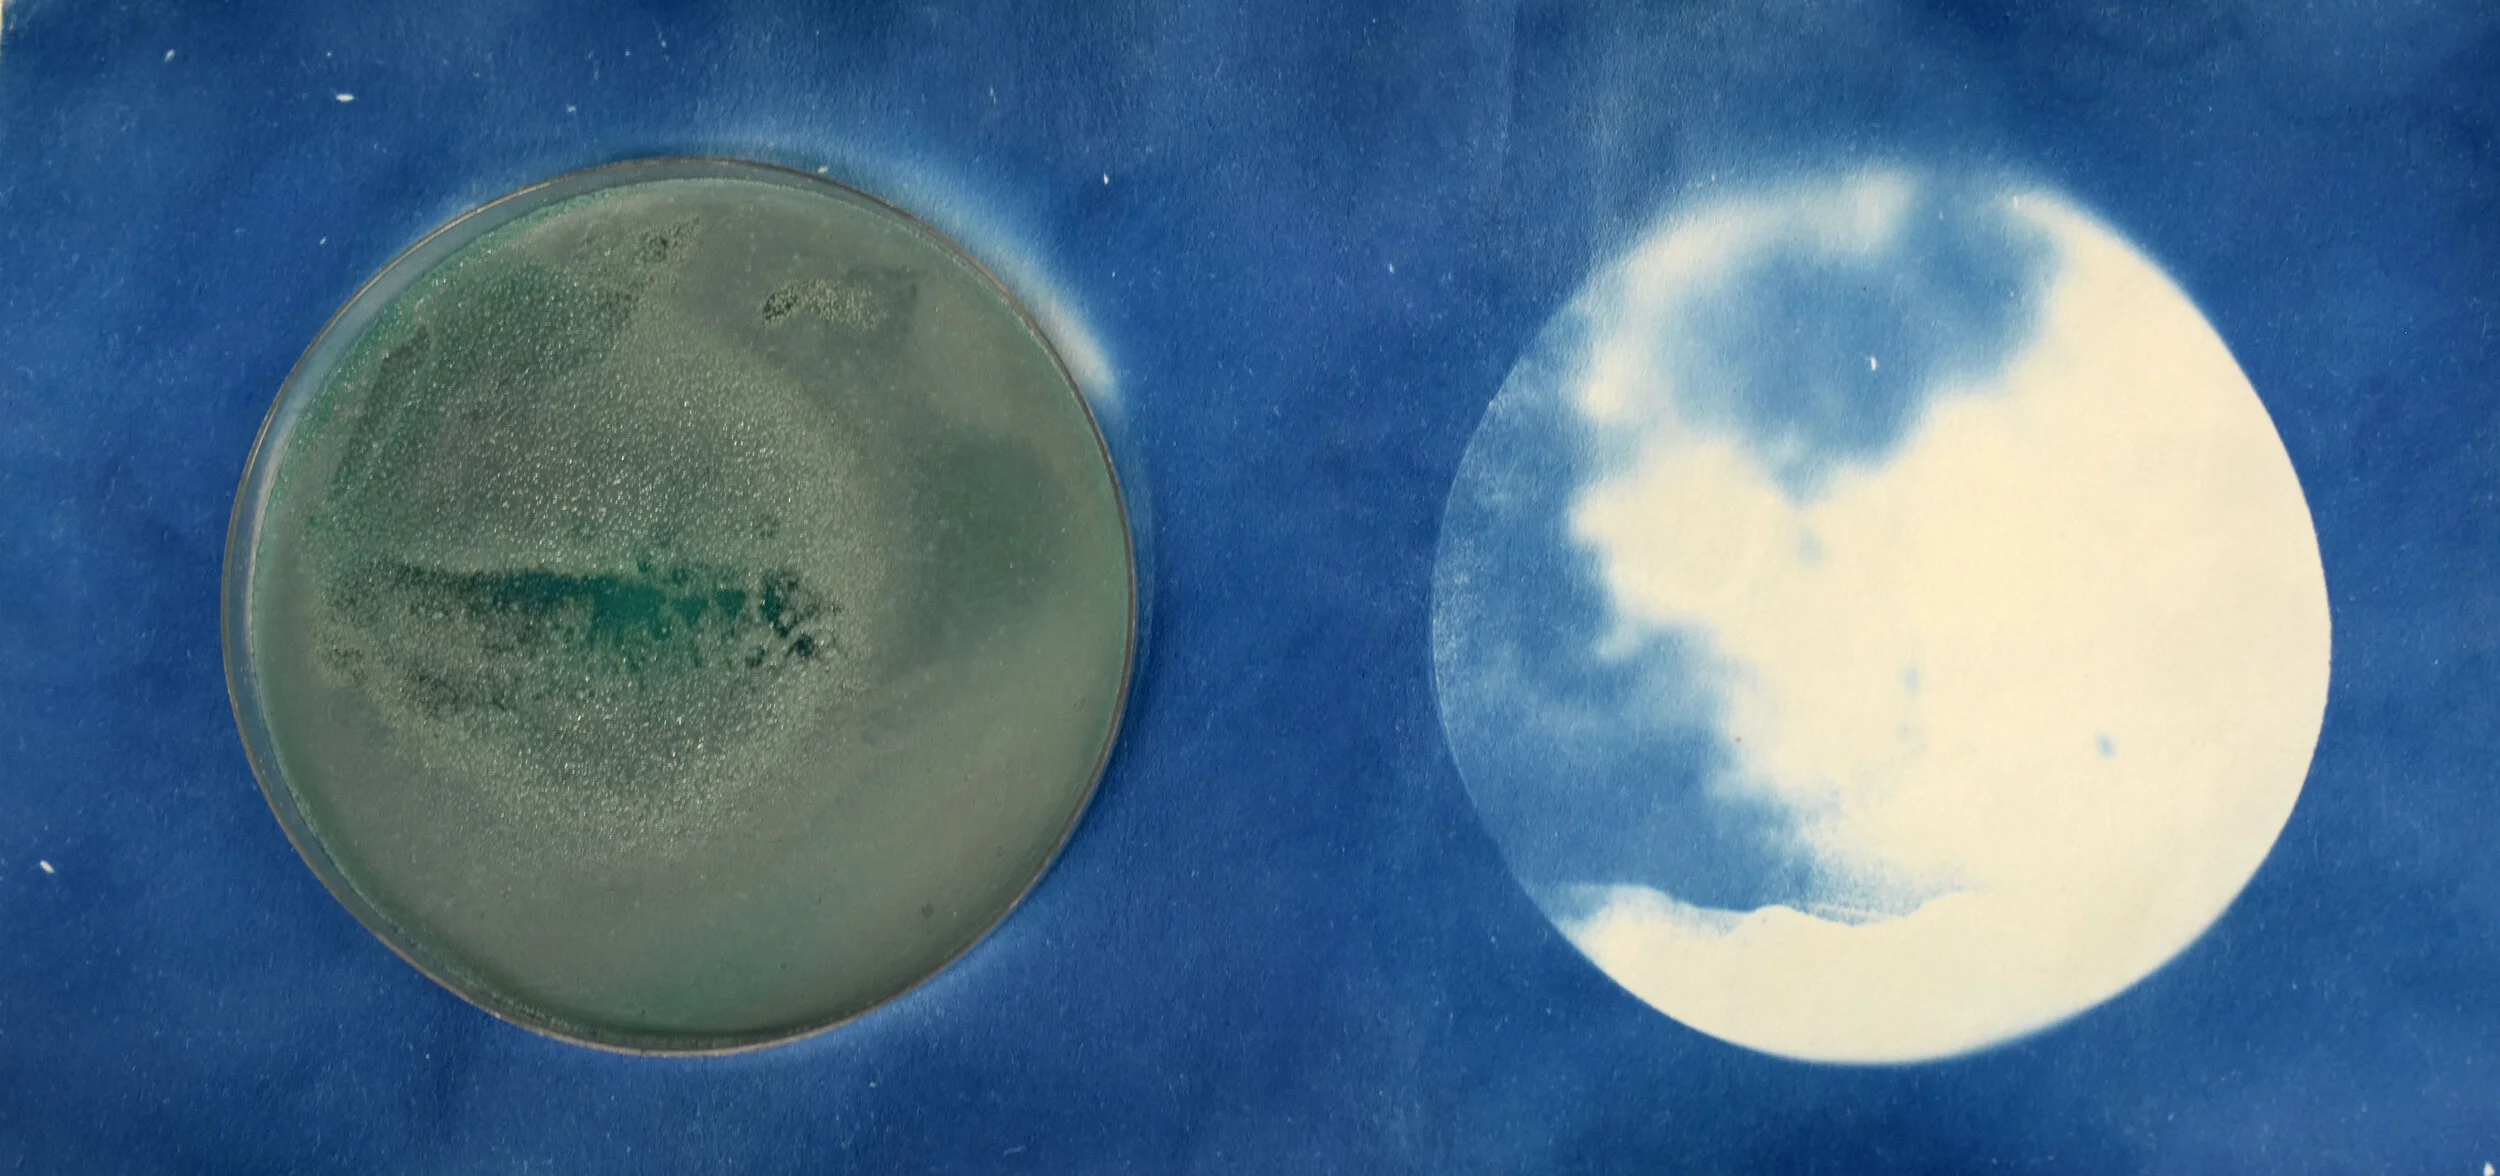

contaminations from the source
kilpisjärvi and ii finland, april-may 2021
ALL RIGHTS / TOUS DROITS © ADAGP, 2021
EN: During the Ars Bioarctica (Bioart Society) and KulttuuriKauppila Art Centre residency programs in Finland, I created a series of bacterial “revelations” in collaboration with two scientists: microbiologist Dr. Minna Männistö and physicist Dr. Antti Kero. To generate a series of in-situ, living photographic images, I exposed colorful strains of bacteria collected in the tundra and soil collected in the arctic landscapes of Kilpisjärvi, Finland to UV light under photographic negatives. The negatives were created from my own photographs of the aurora borealis, in addition to images of data patterns that describe auroral activity: a series of “maps” of the particle collisions in the ionosphere which produce the colorful auroras (provided by KAIRA, the Kilpisjärvi Atmospheric Imaging Receiver Array). I also exposed the bacteria to negatives of topographical maps of the landscapes where I had collected the bacteria samples, letting them producing living maps of their own surroundings. Once all of these images had been “revealed” by the bacteria, I then released them, in their petri dishes, back into the landscapes in which the bacteria samples were initially collected: the water of the Bothnian Bay or the snow of frozen Lake Kilpisjärvi. I filmed and photographed the process of releasing the bacteria back into nature, and watching as the images then evolved after being “contaminated” by other microbes in their source landscape. Converging cosmic and aerial data with microbial life forms, I attempted to poetically reveal the complexity and diversity of these little worlds we ignore.
(all materials were collected from the ocean, nothing was left to pollute or damage the sites where this series was produced).
FR : Au cours de deux résidences de création en Finlande (Ars Bioarctica du Bioart Society et KulttuuriKauppila Art Centre), j’ai développé une technique de révélation photographique aux bactéries, avec l’aide de la microbiologiste Minna Männistö et du physicien Antti Kero (KAIRA, the Kilpisjärvi Atmospheric Imaging Receiver Array). Afin de générer ces images photographiques vivantes in-situ, j’ai exposé des échantillons de bactéries colorées provenant de la toundra et de la terre des paysages arctiques de Kilpisjärvi, Finlande à la lumière UV sous négatifs. Les négatifs ont été aux motifs surtout des aurores boréales que j’ai photographié moi-même, ainsi que des données visuelles relatives aux aurores (des “cartes” produites par des physiciens qui localisent les collisions des particules qui produisent le phénomène visuel de l’aurore boréale). Une fois les images révélées ou réinterprétées par les bactéries, je les ai relâchées, au sein des boîtes de petri, dans les mêmes paysages où elles ont été récoltées : l’eau de la mer de Botnie, la neige du Lac Kilpisjärvi gelé, etc. Ensuite, j’ai photographié et filmé ces tentatives de “retour à la source”, puis l’évolution des images bactériennes lorsqu’elles se mélangeaient avec d’autres microbes. Au travers de cette tentative de faire converger les données insaisissables à la fois du ciel et de la vie microbienne, j’ai voulu révéler la complexité et la diversité des mondes que nous n’apercevons pas.
(tous les matériaux ont été récupérés de la mer : aucun dommage n’a été effectué aux paysages de mes interventions).










Contaminations from the Source, Praava, Finland, May 2021
EN: On a small beach along the Bothnian Bay, I released several Petri dishes containing bacterial “revelations” and cyanotypes on agar plates into the Bothnian Sea, in addition to negative transparencies depicting a self portrait or topographical maps. I filmed and photographed as the waves returned the petri dishes over and over again to the shoreline— making it impossible to pollute the sea with my images.
FR : Sur une petite plage du littoral finlandais, j’ai relâché plusieurs boîtes de petri contenant ces “révélations” bactériennes, ainsi que des cyanotypes sur agar agar dans la mer de Botnie, et des images photographiques sur Rhodoïd (un autoportrait, une carte topographique de la région…). J’ai filmé et photographié le processus de retour des images à leur source naturelle. Les vagues faisaient toujours ramener les boîtes à moi : il s’est avéré impossible de m’en séparer— de polluer la mer avec mes images.
Microbial Topographies, Series II, 2021
details: bacteria prints produced with colorful pigments from Kilpisjärvi and Ii, Finland: photographic images, primarily of topographical maps were re-interpreted by various strains of colorful bacteria, and left to evolve over the course of several weeks.



Contaminations from the Source, Hiue, Finland, May 2021.
EN: Cyanotypes toned with local birch bark and lichen pigments, in addition to my bacterial revelations series, were released into the Bothnian Sea at sunset. The cyanotypes depict photographs I had taken previously of the same landscapes.
(all materials were collected from the ocean, nothing was left to pollute or damage the sites where this series was produced).
FR : Cyanotypes teintés aux pigments d’écorces de bouleau et lichens sur papier, ainsi que ma série de “révélations bactériennes”, ont été relâchés dans la mer de Botnie, au coucher de soleil. Les cyanotypes ont été aux motifs des mêmes paysages que j’avais photographiés.
(tous les matériaux ont été récupérés de la mer : aucun dommage n’a été effectué aux paysages de mes interventions).


















Microbial Auroras, 2021
EN: details: “bacterial revelations” produced in Kilpisjärvi, Finland: my own photographs of the aurora borealis in addition to data patterns indicating auroral activity (provided by KAIRA — the Kilpisjärvi Atmospheric Imaging Receiver Array) were “revealed” or printed with UV light onto colorful, photosensitive bacteria strains.
FR : details : “révélations bactériennes” produites à Kilpisjärvi, Finlande : mes propres photographies de l’aurore boréale, en plus des données visuelles qui témoignent de l’activité des aurores (collisions des particules au sein de l’ionosphère), ont été “révélées” par la lumière UV sur des échantillons de bactéries colorées et photosensibles.












Microbial Topographies, Series I, 2021
EN: details: bacteria prints produced in Kilpisjärvi, Finland: topographical maps of the Malla and Saana Fells (mountains) surrounding the Ars Bioarctica residency program were printed with bacteria collected from those same locations.
FR : détails : “révélations bactériennes” produites à Kilpisjärvi, Finlande : cartes topographiques des Malla et Saana Fells (deux montagnes) qui entouraient la résidence Ars Bioarctica où j’ai réalisé ce projet, en employant des échantillons de bactéries locales.










Microcosmos, Series II, 2021
EN: details: bacteria prints produced with colorful pigments from Kilpisjärvi and Ii, Finland: photographic images, primarily of topographical maps were re-interpreted by various strains of colorful bacteria, and left to evolve over the course of several weeks.
FR : détails : “révélations bactériennes” produites à Kilpisjärvi et Ii, Finlande à motif des cartes topographiques réinterprétés par des échantillons variés de bactéries colorées au cours de plusieurs semaines.
Microcosmos, Series I, 2021
EN: details: cyanotypes and “bacterial revelations” produced with colorful pigments from Kilpisjärvi, Finland: photographic images of auroral and celestial data (visual representations of VLF (very low frequency) recordings of electromagnetic activity in the ionosphere and magnetosphere provided by KAIRA (Kilpisjärvi Atmospheric Imaging Receiver Array) and photographs of the sky and sea were printed onto agar agar and paper.
FR : détails : cyanotypes et “révélations bactériennes” produites à Kilpisjärvi Finlande, à motif des données témoignant de l’activité des aurores boréales et d’autres activités célestes (comme des représentations visuelles des enregistrements VLF — des ondes électromagnétiques à très basse fréquence— de l’ionosphère et la magnétosphère fournis par KAIRA (Kilpisjärvi Atmospheric Imaging Receiver Array) et des photographies du ciel et de la mer toutes imprimées sur agar agar et papier.
black and white














Contaminations from the Source, Illinsaari, Finland, May 2021
EN: On an island in western Finland, I released several Petri dishes containing “bacterial revelations” (or bacteria prints), in addition to transparent prints of photographs taken at the University of Oulu Botanical Museum and Herbarium. The photographs depict lists of endangered bryophytes, envelopes containing samples of lichens from various regions of Finland.
FR : Sur une île à l’ouest de la Finlande, j’ai relâché plusieurs boîtes de petri contenant des “révélations bactériennes” (des images photographiques vivantes) ainsi que des tirages transparents à motif de photographies que j’ai prises au sein de l’herbier du Musée botanique de l’Université d’Oulu. Les images photographiques présentaient des listes d’espèces de bryophytes menacées, ainsi que des envelopes contenant des échantillons de lichens et bryophytes de différentes régions finlandaises.








Contaminations from the Source, Ii, Finland, May 2021
EN: While walking on a floating bog in Ii, Finland, at 2am under the bright light of a supermoon (visual phenomenon that occurs when the moon’s orbit is closest to Earth at the time of the full moon, making it appear much larger than it really is), I placed several Petri dishes containing small LED lights, and transparent photographic prints depicting data regarding endangered plant species (lists of endangered plant bryophytes, etc. collected at the herbarium of the University of Oulu Botanical Museum) that may live in the bog within it.
FR : Tout en marchant sur la couche végétale flottante d’une tourbière à Ii, Finlande à 2h du matin sous la lumière puissante d’un supermoon (un phénomène visuel où la pleine lune a lieu au moment où son orbite est le plus près de la terre, ce qui crée l’illusion que la lune est beaucoup plus grande qu’en réalité), j’ai relâché plusieurs boîtes de petri contenant des petites lumières LED, ainsi que des tirages photographiques transparentes à motif des données concernant les plantes menacées qui vivaient potentiellement dans cette tourbière (une liste d’espèces de bryophytes menacées, etc.) que j’avais collectées dans l’herbier du Musée botanique de l’Université d’Oulu.















Contaminations from the Source,, Iijoki, Finland, May 2021
EN: In the Iijoki river, I placed several Petri dishes containing “bacterial revelations (or bacteria prints) in a circular pattern around a birch tree, photographing the upside-down landscapes produced from the reflections of the Petri dishes and trees.
FR : Dans la rivière Iijoki à l’ouest de la Finlande, j’ai encerclé un bouleau avec plusieurs boîtes de Petri contenant des “révélations bactériennes”. J’ai ensuite photographié les paysages à l’envers produits par les reflets des boîtes de Petri et des arbres.